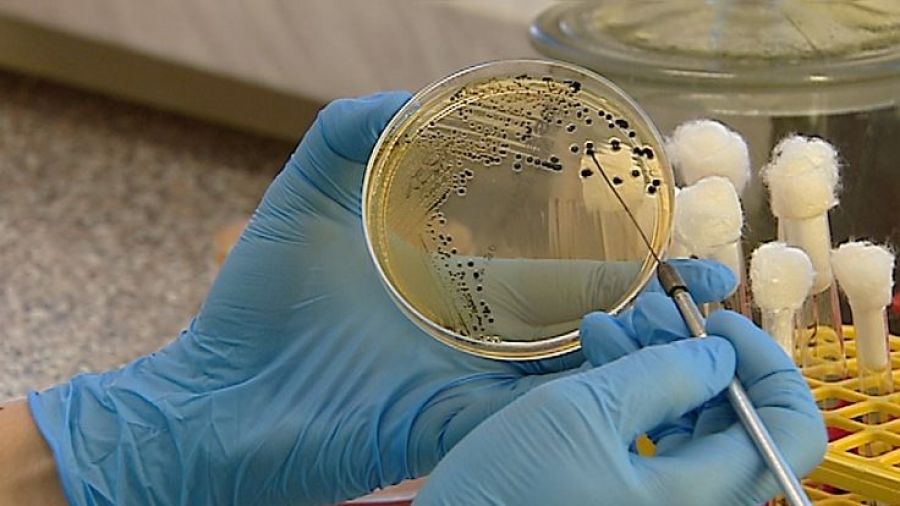

Sprawdzian Z Przyrody Dział 3 Klasa 4 Bakterie

Co to są bakterie? To bardzo małe, jednokomórkowe organizmy. Są tak małe, że nie widzimy ich gołym okiem – potrzebny jest mikroskop!
Bakterie są wszędzie! Znajdziemy je w ziemi, wodzie, powietrzu, a nawet wewnątrz i na ciałach innych organizmów, w tym nas!
Budowa bakterii:
- Ściana komórkowa: Ochronna warstwa na zewnątrz. Daje bakteriom kształt.
- Błona komórkowa: Pod ścianą komórkową. Kontroluje, co wchodzi i wychodzi z bakterii.
- Cytoplazma: Galaretowata substancja wewnątrz bakterii.
- Materiał genetyczny (DNA): Informacja, która mówi bakterii, jak ma działać. Nie ma jądra komórkowego, jak w naszych komórkach.
Kształty bakterii: Bakterie mają różne kształty. Najczęstsze to:
- Kuliste (ziarenkowce): Wyglądają jak małe kuleczki.
- Pałeczkowate (pałeczki): Mają kształt krótkich pałeczek.
- Spiralne (spirale): Wyglądają jak spiralne sprężyny.
Czy bakterie są tylko złe? Nie! Choć niektóre bakterie powodują choroby (np. angina), wiele z nich jest pożytecznych. Na przykład, bakterie w naszych jelitach pomagają nam trawić jedzenie. Bakterie też są używane do produkcji jogurtów i serów!
Pamiętaj, higiena jest bardzo ważna, aby chronić się przed szkodliwymi bakteriami. Myj ręce przed jedzeniem i po wyjściu z toalety!

www.youtube.com

www.youtube.com

www.youtube.com
rzeszow.tvp.pl
wordwall.net
